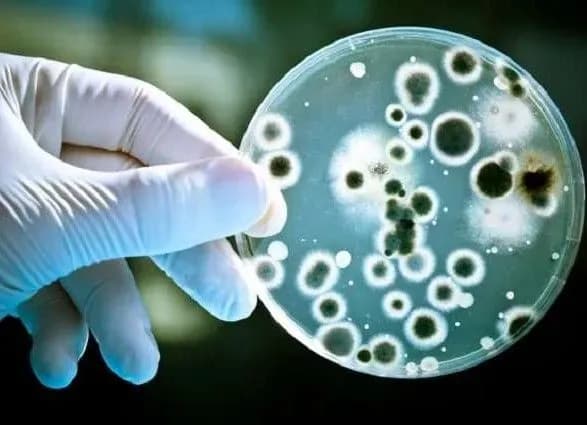
v-ukrayini-tsogo-roku-zareyestruvali-vzhe-3-vipadki-zakhvoryuvannya-na-likhomanku-zakhidnogo-nilu

“За 7 місяців 2018 року в Україні зареєстровано 3 випадки захворювань на геморагічну гарячку Західного Нілу (ГЗН), за аналогічний період 2017 року — 1 випадок. Всі випадки зареєстровані в Полтавській області, внаслідок укусів комарів, інфікованих збудником. Смертельних випадків не зафіксовано”, — йдеться в повідомленні.
Як повідомляв УНН, раніше у Києві виявлено випадок підозри на захворювання гарячкою Західного Нілу. Симптоми захворювання у чоловіка з’явилися після повернення з відпочинку на Кіпрі.
У Центрі громадського здоров'я розповіли, що чоловіка госпіталізували у відділення інфекційної реанімації Олександрівської клінічної лікарні Києва з попереднім діагнозом менінгоенцефаліт, лихоманка невідомого генезу. Аналіз сироватки крові направили до вірусологічної референс-лабораторії, в результаті якого були виявлені антитіла до вірусу лихоманки Західного Нілу. Наразі дослідження тривають.
Зазначимо, гарячка Західного Нілу — це небезпечна вірусна хвороба, що передається через укуси комарів. У тяжких випадках супроводжується гарячкою, запаленням мозкових оболонок і речовини головного мозку, лімфаденопатією, ураженням слизових оболонок, екзантемою. Має літньо-осінню сезонність, частіше нею хворіють сільські жителі, а також любителі полювання, звідки ще одна назва — “качина лихоманка”.
На сьогодні хвороба розповсюджена в багатьох країнах Африки, Азії, Середземномор’я. Окремі спалахи реєструються в країнах Центральної Азії (Казахстан, Туркменія, Таджикистан), Закавказзя (Азербайджан, Вірменія), США, Канаді, Мексиці, країнах Центральної Америки і Карибського басейну, Австралії, зафіксовані випадки в Росії та Україні.
Нагадаємо, на початку вересня Європейський центр профілактики та контролю захворювань повідомив про зростання кількості людей, що заразилися лихоманкою Західного Нілу в ЄС та сусідніх країнах.